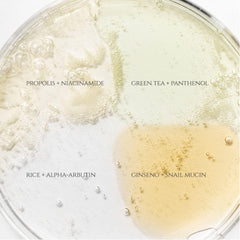
Hanbang Serum Kit with mini-size bestsellers-BEAUTY OF JOSEON-The Cosmetic Store NZ

BEAUTY OF JOSEON HANBANG SERUM DISCOVERY KIT
THE 'HANBANG DISCOVERY KIT' WAS CREATED FOR THOSE WHO WANT TO FIND OUT WHICH OF THE FOUR BOJ SERUMS IS BEST FOR THEIR SKIN.
WHAT IT IS
This is a 10ml mini-size set with 4 types of serums so that you can choose to use or layer them according to your skin type or skin issues. Experience a wonderful journey to find the right product for you before taking the plunge on a full-size bottle.
Calming Serum: Green Tea + Panthenol 10ml
Solution: Green tea leaf water 76% + Panthenol 2%
Notable ingredients: Centella Asiatica Extract, Artemisia Vulgaris Extract, Sodium Hyaluronate
Texture: Watery and lightweight texture
Benefits: Soothing, Calming
Glow Serum : Propolis + Niacinamide 10ml
Solution : Propolis Extract 60% + Niacinamide 2%
Notable ingredients: Betaine Salicylate (BHA), Tamanu Oil, Tea Tree Extract
Texture: Honey-like texture
Benefits: Anti-acne, Anti-inflammation
Glow Deep Serum: Rice + Alpha-Arbutin 10ml
Solution: Rice bran water 68% + Alpha-Arbutin 2%
Notable ingredients: Glycerin, Niacinamide, Soybean Seed Extract, Barley Extract, Rice Extract, Sesame Extract
Texture: Watery and lightweight texture
Benefits: Anti-pigmentation, Brightening
Revive Serum : Ginseng + Snail Mucin 10ml
Solution: Ginseng Root Water 63% + Snail Mucin 3%
Notable ingredients: Ginseng Root Extract, Adenosine, Matsutake Extract
Texture: Lightweight, Mucin-like texture
Benefits: Anti-wrinkle, Anti-pigmentation
HOW TO USE
Apply 2-3 drops of serum onto the skin and pat gently to help absorption.
INGREDIENTS
CAUTION
For external use only.
Avoid contact with eyes.
Discontinue use if rash, redness, or itching occurs. Consult your physician if irritation persists.
We highly recommend to conduct a skin patch test on your arms before applying it directly to the face to avoid any allergic reactions.
Store in a cool and dry place.
Keep it out of the reach of children.
PLEASE NOTE
Ingredients are subject to change at manufacturer's discretion. For the most complete and up-to date list of ingredients, please refer to the product packaging.
Loading
Loading